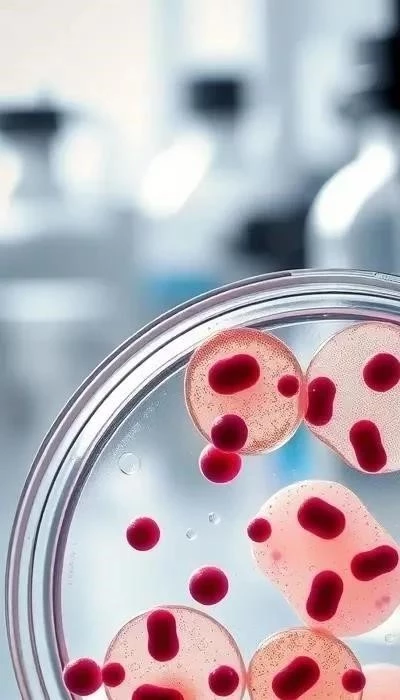

Цервицит – это воспаление шейки матки, которое, к сожалению, остается актуальной проблемой женского здоровья и в 2026 году. Распространенность этого заболевания вызывает серьезную обеспокоенность, поскольку оно может приводить к различным осложнениям, включая бесплодие и внематочную беременность. Своевременная диагностика и адекватное лечение цервицита крайне важны для сохранения репродуктивного здоровья женщины и предотвращения негативных последствий. В данной статье мы подробно рассмотрим причины, симптомы, методы диагностики и современные подходы к лечению и профилактике цервицита, чтобы помочь вам разобраться в этой проблеме и принять осознанные решения о своем здоровье.
Важно помнить: Опасность заболевания заключается в его часто бессимптомном течении на ранних стадиях, что затрудняет своевременное обращение за медицинской помощью. Поэтому регулярные гинекологические осмотры являются ключевым элементом профилактики и раннего выявления цервицита.
Как отмечают врачи, выбор метода лечения цервицита зависит от причины воспаления и особенностей его течения. Если патология развилась в результате дефицита эстрогенов, то предпочтение отдается местной терапии цервицита свечами, например, Овестин. Применение этого препарата способствует восстановлению вагинальной кислотности и микрофлоры, а также нормализации состояния слизистой.
Соответственно, для постановки диагноза врач должен определить, что спровоцировало появление таких признаков, убедиться, что это именно цервицит, а также понять, от чего он появился. Для этого используются следующие методы обследования: ПЦР для определения конкретных возбудителей (в частности, ВПЧ и других вирусов).
Параллельно с терапией пациентки проводится обследование ее партнера и при необходимости ему тоже назначается лечение. В этот период необходимо исключить секс или пользоваться барьерными средствами контрацепции.

Если болезнь уже имеет хронический характер, то медикаментозное лечение малоэффективно, и пациенток направляют на хирургическое лечение – лазерную вапоризацию и радиоволновую терапию.
Цервицит относится к числу тех заболеваний, при которых важно ликвидировать факторы, провоцирующие его (иммунные, гормональные, анатомические или обменные нарушения).
Врач планирует лечение в зависимости от причинных факторов, истории болезни, тяжести симптомов и степени заболевания. Цервицит, вызванный неблагоприятной реакцией на спермицид или средства женской гигиены, не требует приема лекарств, но может потребовать от пациента прекращения использования таких средств.

Цервицит, воспаление шейки матки, продолжает оставаться значимой проблемой в гинекологии в 2026 году. По данным статистики, заболеваемость цервицитом неуклонно растет, оказывая существенное влияние на женское здоровье и репродуктивную функцию. Своевременная диагностика и эффективное лечение крайне важны, поскольку запущенные формы могут привести к серьезным осложнениям, включая бесплодие и хронические тазовые боли. В данной статье мы подробно рассмотрим современные подходы к выявлению, лечению и профилактике цервицита, чтобы помочь женщинам сохранить здоровье и качество жизни. Мы обсудим причины возникновения, характерные симптомы, а также передовые методы диагностики и терапии, доступные в 2026 году.
Причины цервицита: Инфекционные и неинфекционные факторы
Цервицит может быть вызван широким спектром факторов, которые условно делятся на инфекционные и неинфекционные. Инфекционные причины включают бактериальные, вирусные, грибковые и паразитарные инфекции. Неинфекционные факторы включают аллергические реакции, механические травмы шейки матки и химическое раздражение. Особую роль в развитии цервицита играют инфекции, передающиеся половым путем (ИППП), такие как хламидиоз, гонорея и трихомониаз. Важно учитывать и факторы риска, такие как множественные половые партнеры и отсутствие барьерной контрацепции.
Инфекционные причины: Бактерии, вирусы, грибки и паразиты
Бактериальный цервицит часто вызывается хламидиями и гонококками – основными возбудителями ИППП. Вирусные инфекции, в частности, вирус папилломы человека (ВПЧ), также могут провоцировать воспаление. Грибковые инфекции, такие как кандидоз, реже являются первичной причиной, но могут усугублять течение цервицита. Паразитарные инфекции, например, трихомониаз, также вносят свой вклад в развитие заболевания.
Неинфекционные причины: Аллергия, травмы и химическое раздражение
Аллергические реакции на латекс презервативов, спермициды или средства женской гигиены могут вызывать воспаление шейки матки. Травмы, полученные во время родов, гинекологических процедур или полового акта, также могут спровоцировать цервицит. Химическое раздражение от агрессивных моющих средств или вагинальных душей также является возможной причиной.
Роль инфекций, передающихся половым путем (ИППП) в развитии цервицита
ИППП, такие как хламидиоз, гонорея, трихомониаз и вирус папилломы человека (ВПЧ), являются одними из наиболее частых причин цервицита. Эти инфекции могут вызывать воспаление шейки матки, приводя к характерным симптомам. Важно помнить, что своевременная диагностика и лечение ИППП необходимы для предотвращения осложнений.
Факторы риска развития цервицита
К факторам риска развития цервицита относятся: раннее начало половой жизни, частая смена половых партнеров, отсутствие барьерной контрацепции, курение, ослабленный иммунитет и гормональные нарушения. Важно учитывать, что эти факторы могут повышать вероятность развития воспаления.
Симптомы цервицита: Острый и хронический процесс
Острый цервицит проявляется выраженными симптомами: обильные гнойные выделения из влагалища, зуд, жжение, дискомфорт при половом акте, боли внизу живота. Хронический процесс протекает менее ярко, симптомы сглажены или отсутствуют вовсе, что затрудняет диагностику.
Характер выделений из влагалища при цервиците
Выделения при цервиците могут быть различны: от прозрачных и водянистых до гнойных, желтоватых или зеленоватых. Часто наблюдается изменение запаха, который может стать неприятным. Интенсивность выделений варьируется в зависимости от стадии и причины воспаления.
Профилактика цервицита: Укрепление иммунитета и здоровый образ жизни
Профилактика цервицита включает в себя поддержание здорового образа жизни, укрепление иммунитета и соблюдение правил гигиены. Важно избегать случайных половых связей и использовать барьерные методы контрацепции. Регулярные гинекологические осмотры – залог раннего выявления и успешного лечения.
